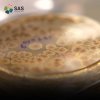

Passion ที่มาและขั้นตอนการผลิตจุลินทรีย์โพรไบโอติก

จุลินทรีย์คือสิ่งมีชีวิตตัวเล็กๆ ที่มีอยู่ทุกๆ ที่ในธรรมชาติ ไม่ว่าจะเป็นในสภาวะสิ่งแวดล้อม ต่างๆ น้ำ ดิน อากาศ ในสิ่งมีชีวิต อาหาร หรือแม้กระทั้งในบริเวณที่คาดไม่ถึงว่าจะมีสิ่งมีชีวิตอาศัยอยู่ได้ เช่น ทะเลที่มีรสเค็มจัด ขั้วโลก น้ำพุร้อน หรือ สภาวะที่ไม่มีออกซิเจน การค้นหาและคัดแยกจุลินทรีย์เพื่อนำมาใช้ประโยชน์จึงสำคัญ เนื่องจากจุลินทรีย์บางชนิดมีคุณสมบัติที่แตกต่างกัน บางชนิดก่อโรค บางชนิดมีประโยชน์ ซึ่งเราจะเรียก จุลินทรีย์ที่มีประโยชน์เหล่านั้นว่า โพรไบโอติก
บริษัท สยาม อะกริ ซัพพลาย จำกัด หรือ SAS
ดำเนินธุรกิจด้านการเกษตรในกลุ่มวัตถุดิบอาหารและวัตถุดิบอาหารสัตว์ในประเทศไทยมานานนับสิบปี
ได้ริเริ่มสร้างศูนย์วิจัยและพัฒนา (R&D) สำหรับการค้นคว้าวิจัยเทคโนโลยีชีวภาพและจัดตั้ง Bio Bank หรือคลังจุลินทรีย์ เพื่อเป็นสถานที่จัดเก็บเชื้อจุลินทรีย์สายพันธุ์ที่เป็นประโยชน์สูงสุด และแข็งแรงมีคุณภาพ ให้อยู่ในสภาวะที่เหมาะสม สมบูรณ์เพื่อนำมาใช้พัฒนาขบวนการผลิตและเพิ่มคุณภาพผลิตภัณฑ์ดั้งเดิมของบริษัท เพื่อตอบโจทย์ความต้องการของการแก้ปัญหาโดยการใช้จุลินทรีย์จากธรรมชาติ ทั้งเรื่องสิ่งแวดล้อม ปศุสัตว์ สุขภาพสัตว์เลี้ยง ไปจนถึงการลดความเสี่ยงต่อการเกิดโรคต่างๆ ทั้งในคนและสัตว์ ในสังคมโดยมุ่งเน้น พัฒนาสายพันธุ์ที่มีความเหมาะสมต่อสภวาะสิ่งแวดล้อมใกล้เคียงกับชาวเอเชีย โดยเฉพาะจุลินทรีย์สายพันธุ์เพื่อคนไทย
บริษัท สยาม อะกริ ซัพพลาย จำกัด นับเป็นหนึ่งในผู้บุกเบิกด้านเทคโนโลยีชีวภาพ ที่ ใส่ใจ ตั้งแต่จุดเริ่มต้นเล็กๆ เพื่อสร้างนวัตกรรมเพื่อสุขภาพ สำหรับคน, สัตว์เลี้ยง, สัตว์เศรษฐกิจ, เกษตรกรรมและสิ่งแวดล้อม ขับเคลื่อนด้วยผู้คนซึ่งมีวิสัยทัศน์สอดคล้องกัน ช่วยกันสร้างสรรค์พื้นที่สำหรับคนรุ่นใหม่ และมีบรรยากาศการทำงานที่เปิดกว้าง เพื่อสนับสนุนศักยภาพของเพื่อนร่วมทีมทุกคน พร้อมเพิ่มโอกาสทางธุรกิจในอนาคต พัฒนาผลิตภัณฑ์ และนวัตกรรมใหม่ๆที่สามารถส่งมอบคุณภาพชีวิตที่ดีและความสุขที่ยั่งยืนของทุกชีวิตและเป็นการช่วยขับเคลื่อนเศรษฐกิจไทยได้อย่างแท้จริง
กว่าจะได้จุลินทรีย์ที่ดีมีคุณภาพ SAS มีการคัดสรรค์อย่างพิถีพิถัน ดังนี้
1. การคัดเลือกและจำแนกเชื้อจุลินทรีย์โพรไบโอติก
SAS คัดสรรค์จุลินทรีย์ที่ดีมีประโยชน์ จากการเก็บตัวอย่างอาหารหมักดองทั่วประเทศ และทำการคัดแยกโดยวิธีการจำแนกลักษณะทางจุลชีววิทยาต่างๆ เช่น การศึกษารูปร่าง คุณสมบัติทางเคมี ลักษณะทางพันธุ์กรรม (16s rRNA) จนได้มาเป็นจุลินทรีย์โพรไบโอติกแต่ละสายพันธุ์ ที่มีความเหมาะสม แข็งแรง และมีความบริสุทธิ์ ตามประกาศการใช้จุลินทรีย์โพรไบโอติกในอาหาร จากนั้น เก็บรักษาไว้อย่างดีภายใต้อุณหภูมิ -196 องศาเซลเซียสในคลังจุลินทรีย์ (Bio Bank) ภายใต้หลักความปลอดภัยที่ได้มาตรฐาน นอกจากนี้ SAS ยังไม่หยุดยั้งในการค้นหาสายพันธุ์จุลินทรีย์ชนิดใหม่ๆ จึงได้มีการร่วมมือกับองค์ภาครัฐบาลต่างๆ อาทิ เช่น มหาวิทยาลัย ในการรับการถ่ายทอดทอดจุลินทรีย์ที่มีคุณสมบัติพิเศษ ต่างๆ เพื่อนำมาพัฒนาผลิตภัณฑ์ต่อยอดสินค้าใหม่ๆ เพื่อตอบโจทย์และการแก้ไขปัญหาในปัจจุบัน
- ขั้นตอนการทดสอบคุณสมบัติโพรไบโอติก
โดยทั่วไปแล้ว เมื่อเรารับประทานโพรไบโอติกเข้าสู่ร่างกายผ่านทางระบบทางเดินอาหาร โพรไบโอติกที่มีชีวิตจะผ่านเข้าทางช่องปากหลอดลม กระเพาะอาหารที่มีความเป็นกรดสูง และไปเจริญเติบโตและทำงานที่บริเวณลำไส้ ดังนั้น โพรไบโอติกที่ผ่านการคัดสรรจาก SAS จะต้องมีคุณสมบัติทนต่อกรดในกระเพาะอาหารและเกลือน้ำดีในลำไส้เพื่อที่จะอยู่รอดและมีคุณสมบัติในการยับยั้งเชื้อจุลินทรีย์ก่อโรคได้
- การทดสอบความทนทานต่อสภาวะความเป็นกรดเทียบเท่าในกระเพาะอาหาร
การทดลองนี้จะเป็นการทดสอบความสามารถในการทดกรดของจุลินทรีย์สายพันธุ์ต่างๆ โดยการนำจุลินทรีย์จากคลัง Bio Bank มาเพาะเลี้ยงบนอาหารเลี้ยงเชื้อ จากนั้นทดสอบด้วยการเติม กรดที่มีค่า pH 2-3 บ่มที่ อุณหภูมิ 37 องศาเซลเซียส เป็นเวลา 3 ชั่วโมง ซึ่งเป็นการจำลองสภาวะในกระเพาะอาหารของมนุษย์ จากนั้นตรวจสอบการรอดชีวิตของแต่ละสายพันธุ์ต่อไป
- การทดสอบความทนทานต่อเกลือน้ำดี
การทดลองนี้จะเป็นการทดสอบความสามารถในการทดต่อเกลือน้ำดีของจุลินทรีย์สายพันธุ์ต่างๆ โดยการนำจุลินทรีย์จากคลัง Bio Bank มาเพาะเลี้ยงบนอาหารเลี้ยงเชื้อ จากนั้นทดสอบด้วยการเติม Bile salt บ่มที่ อุณหภูมิ 37 องศาเซลเซียส เป็นเวลา 3 ชั่วโมง ซึ่งเป็นการจำลองสภาวะในในลำไส้ของมนุษย์ จากนั้นตรวจสอบการรอดชีวิติของแต่ละสายพันธุ์ต่อไป
- การทดสอบประสิทธิภาพการยับยั้งแบคทีเรียก่อโรคทางเดินอาหาร
ประโยชน์พื้นฐานสำคัญของโพรไบโอติกนั้น คือการที่โพรไบโอติกในลำไส้จะต้องมีความสามารถในการยับยั้งเชื้อก่อโรคภายนะบบทางเดินอาหารได้ ดังนั้นจึงมีการตรวจสอบความสามาถดังกล่าว โดยการนำจุลินทรีย์จากคลัง Bio Bank มาเพาะเลี้ยงบนอาหารเลี้ยงเชื้อ จากนั้นทดสอบด้วยการหยดเชื้อโพรไบโอติกลงบนกระดาษที่มีการเพาะเชื้อก่อโดรคอยุ่ เช่น เชื้อ E.coli หรือ Salmonella ที่อุณหภูมิ 37 องศาเซลเซียส เป็นเวลา 24 ชั่วโมง ถ้าโพรไบโอติก มีคุณสมบัติการยับยั้งเชื้อก่อโรคเหล่านั้น บริเวณที่หยดโพรไบโอติก จะเกิดวงใสรอบๆ โพรไบโอติก หรือที่เรียกว่า Clear zone นั้นเอง
โดย แบรนด์ bioCRAFT ภายในบริษัท สยาม อะกริ ซัพพลาย จำกัด หรือ SAS คิดคำนึงถึงความปลอดภัยของผู้บริโภคเป็นหลักจึงสร้างสรรค์ผลิตภัณฑ์โพรไบโอติกเพื่อดูแลสุขภาพคนไทย โดยนำองค์ความรู้เฉพาะด้านที่เราเชี่ยวชาญพร้อมทีมวิจัยคัดสรรอย่างพิถีพิถันเฉพาะโพรไบโอติกที่มีคุณภาพจากศูนย์วิจัยของเราเอง และทดสอบประสิทธิภาพการทำงานของโพรไบโอติกจากศูนย์วิจัยและพัฒนา (R&D) ที่มีเครื่องมือที่ทันสมัย สะอาด ปลอดภัย ได้รับมาตรฐานสากล เพื่อส่งมอบผลิตโพรไบโอติกที่ดีมคุณภาพสู่ผู้บริโภค